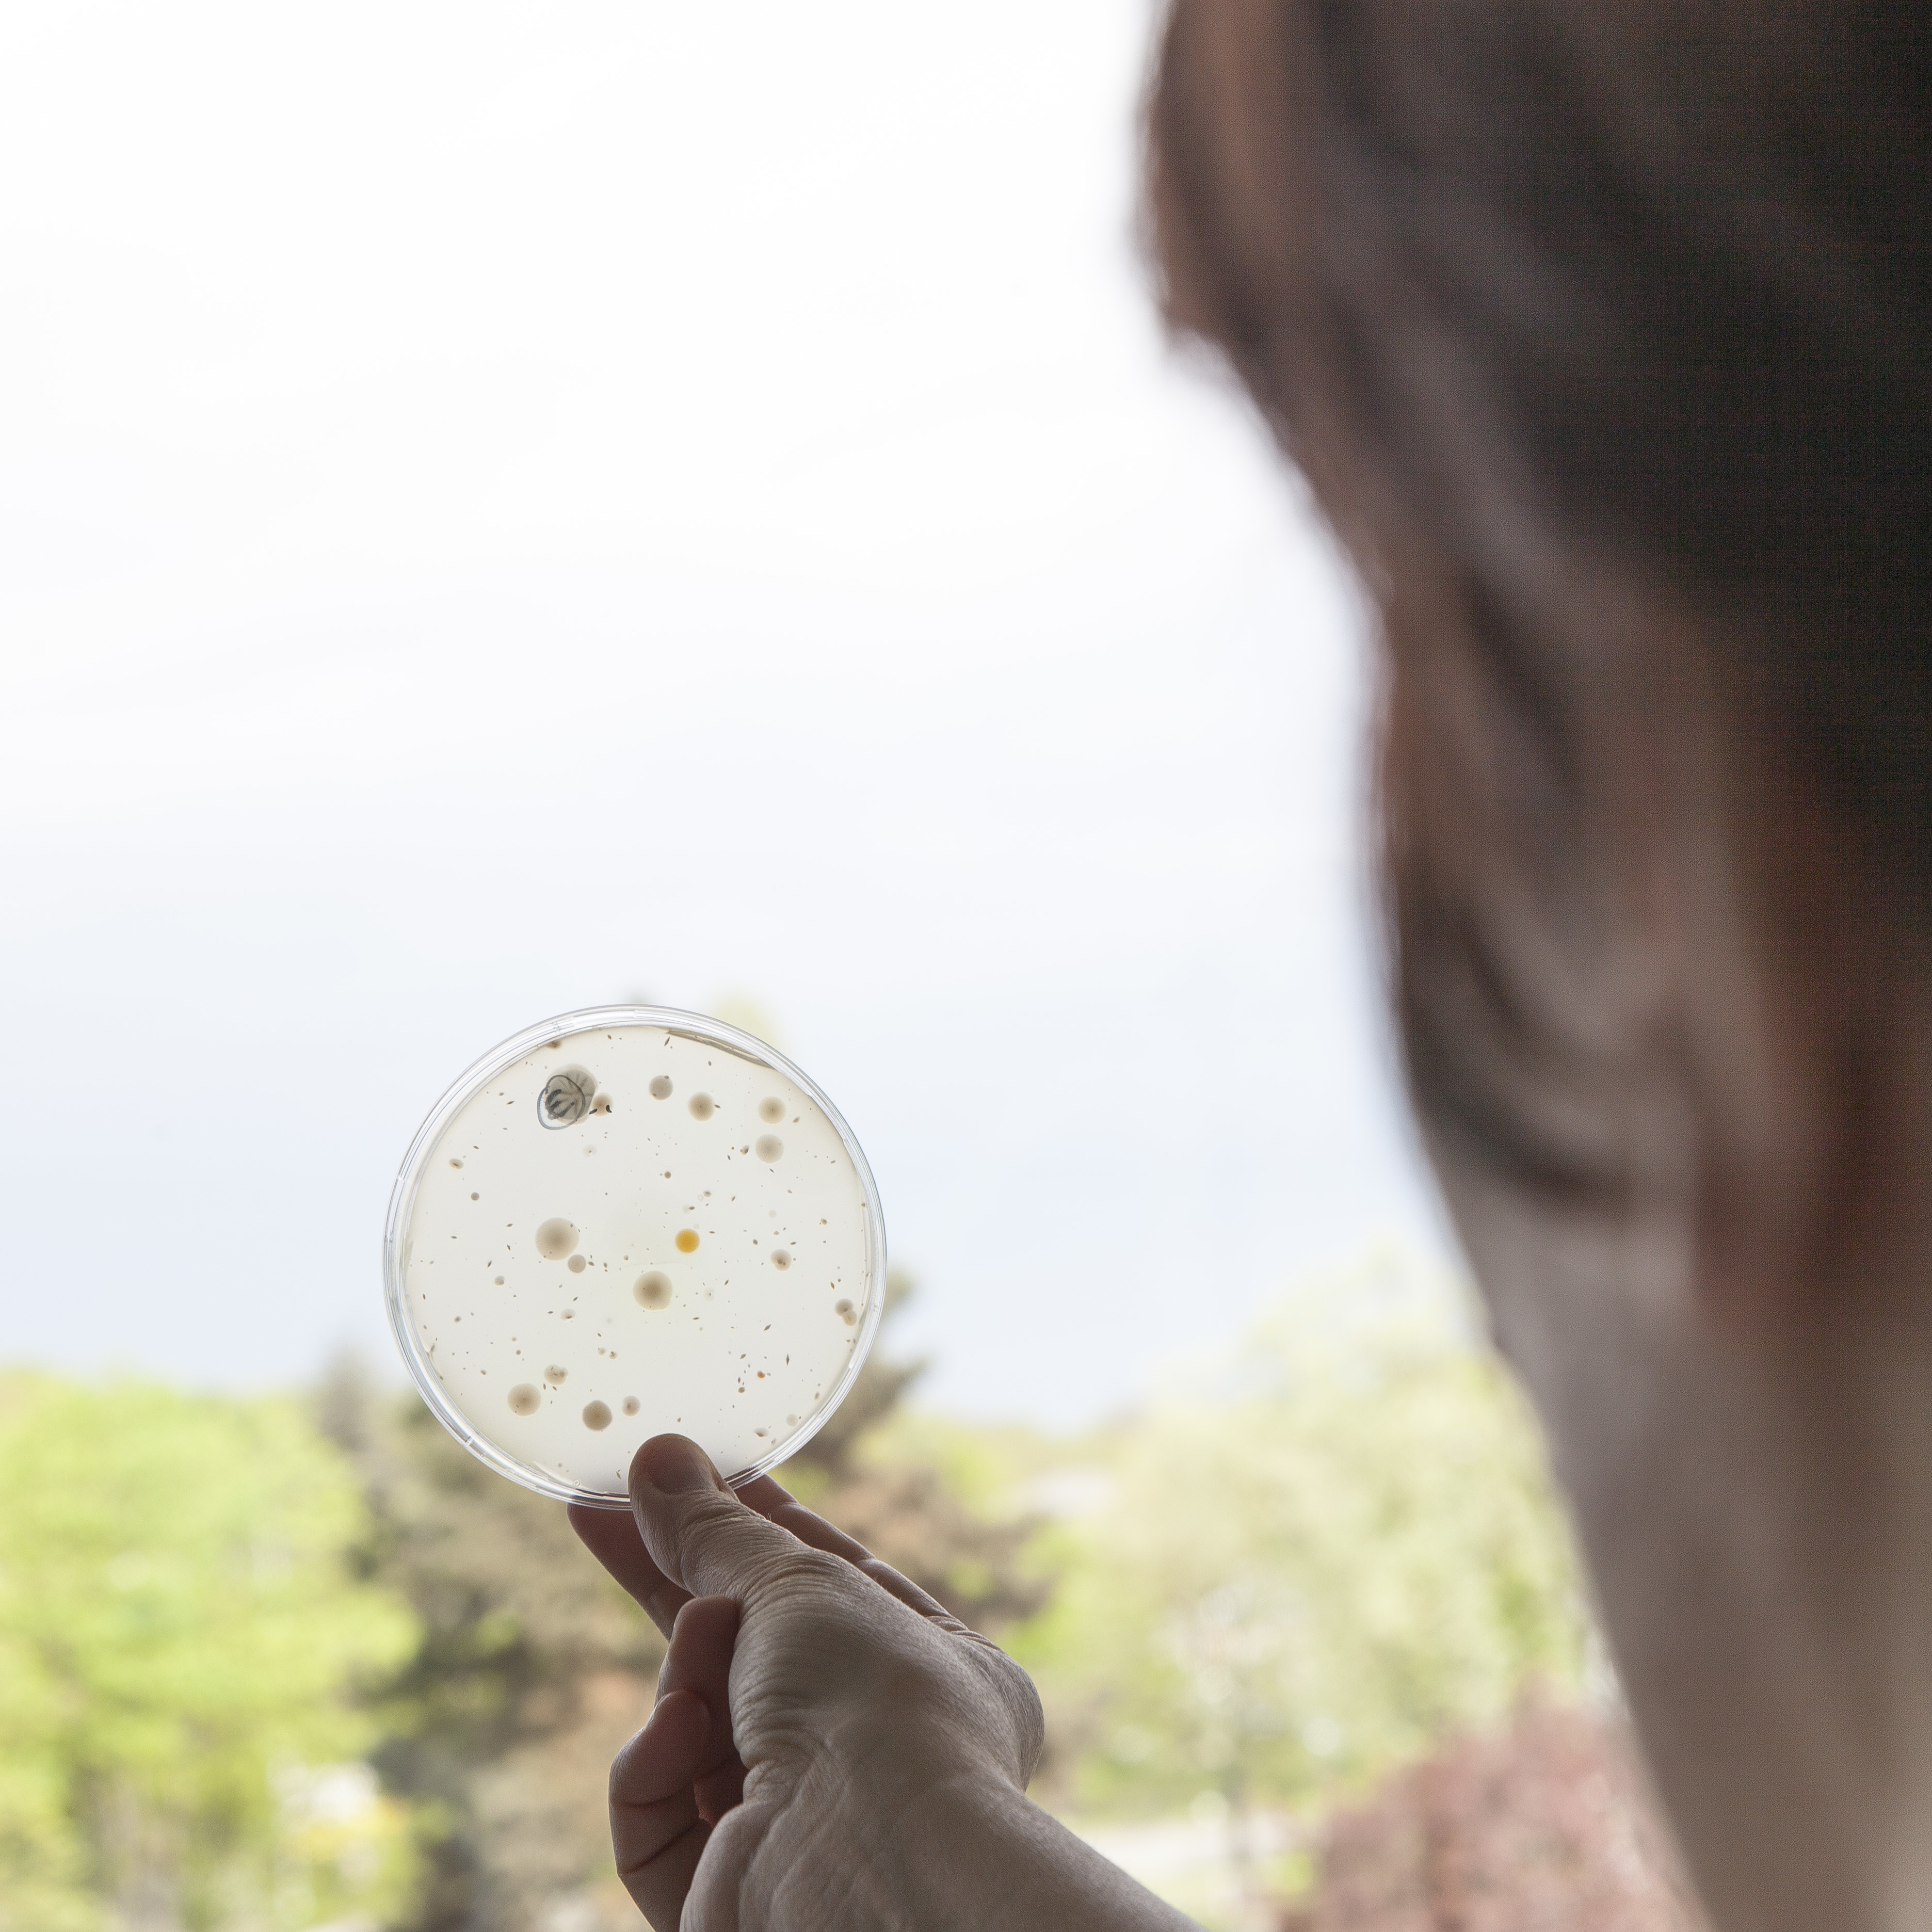

BioImpulse : une nouvelle génération de colles biosourcées et performantes
Le projet BioImpulse, coordonné par Michelin – ResiCare, démontre la capacité des biotechnologies industrielles à produire une nouvelle génération de colles biosourcées, performantes et sans substances préoccupantes pour la santé.
BioImpulse : les biotechnologies au service d’une chimie plus durable
Après six années de recherche collaborative, le projet BioImpulse confirme la compétitivité des biotechnologies industrielles et ouvre la voie à une nouvelle génération de colles performantes, biosourcées et exemptes de substances préoccupantes (SVHC).
Initié par Michelin et sa marque ResiCare, le projet réunit des partenaires publics et privés autour d’un objectif commun : développer une résine adhésive durable à partir d’une molécule d’intérêt biosourcée, jusqu’alors produite uniquement par voie pétrochimique.
Une innovation technologique majeure
Grâce à un procédé unique de fermentation et de purification, les partenaires du projet ont réussi à produire industriellement cette molécule biosourcée à une échelle de 200 m³ — une première en Europe.
Cette avancée permet à ResiCare de formuler de nouvelles résines adhésives compétitives, réduisant l’usage de ressources fossiles tout en maintenant un haut niveau de performance.
Les premières applications concrètes concernent :
-
une formule pour le contreplaqué, proche du lancement commercial,
-
une formule pour composites carbone/carbone, actuellement en évaluation,
-
et un potentiel élargi pour d’autres usages (panneaux de bois, isolants, composites, textiles techniques…).
Une collaboration d’excellence
Le projet BioImpulse (28 M€, 2019–2025) a mobilisé cinq partenaires clés :
-
Michelin (ResiCare) – coordinateur et concepteur des résines,
-
Leaf by Lesaffre – optimisation du procédé de fermentation,
-
Institut technologique FCBA – caractérisation et mise en œuvre des résines,
-
INSA Toulouse (CRITT Bio-Industries, LGC) – développement des procédés de purification,
-
INRAE (TWB, TBI) – conception des souches microbiennes et optimisation des voies de production.
S’y sont ajoutés Alderys (Givaudan) pour la conception de la souche de levure industrielle et ARD (groupe Vivescia) pour la mise à l’échelle du procédé sur son démonstrateur BioDémo.
Une avancée pour la chimie verte européenne
« BioImpulse prouve qu’il est possible de produire à l’échelle industrielle une molécule biosourcée longtemps dépendante du pétro-sourcé. C’est une étape décisive pour l’innovation et la compétitivité de la chimie verte en Europe », souligne Sébastien RiffLART, responsable du programme chez ResiCare.
Fort de cette réussite, les partenaires étudient désormais la création d’un démonstrateur industriel, pour passer de la preuve de concept à la production à grande échelle.

Biolmpulse est un projet soutenu par l'ADEME (Agence de l'environnement et de la maîtrise de l'énergie) dans le cadre du Programme d'investissements d'avenir.